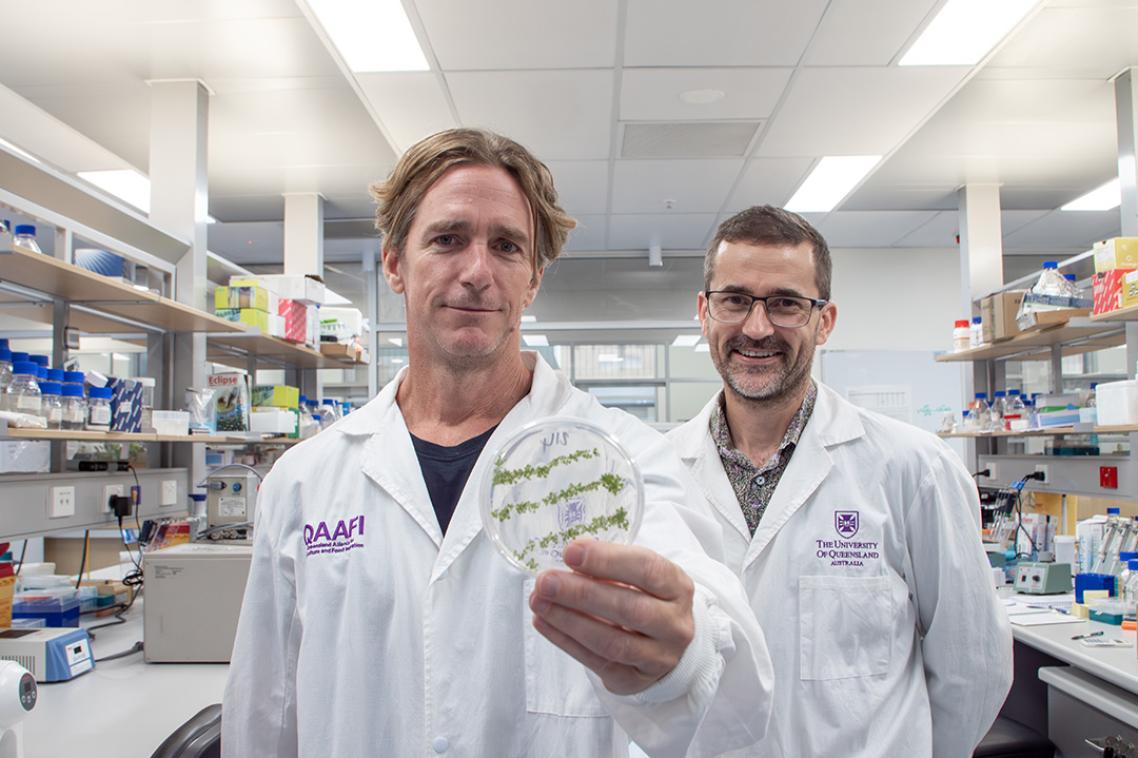

UQ Researchers Reveal RNA-Based Biopesticides Can Travel from Leaves to Roots
February 18, 2026| |
Researchers at the University of Queensland have made a breakthrough discovery revealing that RNA-based biopesticides sprayed on leaves can travel systemically through a plant to its roots. This finding challenges long-held scientific assumptions and opens the door to protecting crops from underground threats such as nematodes and fungi with sustainable, chemical-free sprays.
The study, led by Dr. Chris Brosnan at the Queensland Alliance for Agriculture and Food Innovation (QAAFI), found that double-stranded RNA (dsRNA) does not simply enter individual cells where it is applied. Instead, it moves between cells and throughout the plant's vascular system as an intact molecule. This systemic mobility is a game-changer for agricultural technology, as it provides a potential delivery mechanism for biopesticides to reach deep into root systems, an area that has historically been incredibly difficult to treat with traditional sprays.
By using RNA interference (RNAi) to shut down essential genes in specific pests without harming the plant or beneficial insects, this technology offers a targeted alternative to synthetic chemicals. QAAFI's Dr. Donald Gardiner noted that the research challenges the dogma that RNA is unstable and difficult to take up in soil, where it is often fragile and easily degraded. By moving through the plant's own tissues rather than the surrounding environment, the RNA-based treatment could soon provide a powerful new tool to safeguard global food security against previously out-of-reach pathogens.
For more details, read the article on The University of Queensland News.
| |
You might also like:
- Canada Approves RNAi Biopesticide Technology Field Study
- Scientists Review RNAi-induced Effects in GM Plants
- Pocket K No. 34: RNAi for Crop Improvement
Biotech Updates is a weekly newsletter of ISAAA, a not-for-profit organization. It is distributed for free to over 22,000 subscribers worldwide to inform them about the key developments in biosciences, especially in biotechnology. Your support will help us in our mission to feed the world with knowledge. You can help by donating as little as $10.
-
See more articles:
-
Plant
- Gene Editing Boosts Drought Tolerance in Sugarcane
- Negative GMO Perceptions Could Influence Gene-Edited Crop Acceptance
- Pangenome Reveals Secrets to Breeding Better Cucumbers
- Shandong Agricultural University Researchers Redefine Green Revolution Genes for Modern Wheat
- ISAAA Webinar: Global Status of Commercialized Biotech/GM Crops in 2024
- Experts Develop Grapefruit Without the Bitterness
- USDA Opens Public Comment on Genetically Engineered Apple T1190
-
Environment
- UQ Researchers Reveal RNA-Based Biopesticides Can Travel from Leaves to Roots
-
Read the latest: - Biotech Updates (April 8, 2026)
- Gene Editing Supplement (March 25, 2026)
- Gene Drive Supplement (February 22, 2023)
-
Subscribe to BU: - Share
- Tweet